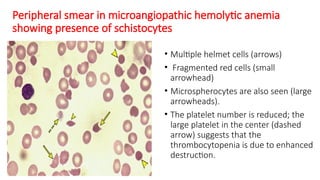
Peripheral smear in microangiopathic hemolytic anemia
showing presence of schistocytes
• Multiple helmet cells (arrows)
• Fragmented red cells (small
arrowhead)
• Microspherocytes are also seen (large
arrowheads).
• The platelet number is reduced; the
large platelet in the center (dashed
arrow) suggests that the
thrombocytopenia is due to enhanced
destruction.

Disseminated intravascular coagulation (DIC) is an acquired syndrome characterized by excessive coagulation leading to both hemorrhage and thrombosis, occurring in 30-50% of sepsis patients. It has a variety of causes including infections, injuries, malignancies, and congenital disorders, with significant risk factors in neonates due to their immature coagulation systems. Early identification and management are crucial as DIC can rapidly progress to life-threatening multiorgan failure.

![Diagnosis
Consider the diagnosis of DIC if all the following criteria are met:
The patient has an underlying condition that predisposes them to DIC (eg,
infection, trauma, malignancy)
Laboratory testing is consistent with DIC (ie, thrombocytopenia plus
coagulation factor consumption [prolonged PT and aPTT, low fibrinogen] and
fibrinolysis [elevated D-dimer])
No other etiology for these findings has been identified
• Clinical evidence of bleeding or thrombosis are supportive of the diagnosis but
are not required for diagnosis.](https://image.slidesharecdn.com/disseminatedintravascularcoagulationdic-240927160326-950c0ddc/85/DISSEMINATED-INTRAVASCULAR-COAGULATION-DIC-IN-CHILDREN-pptx-21-320.jpg)



